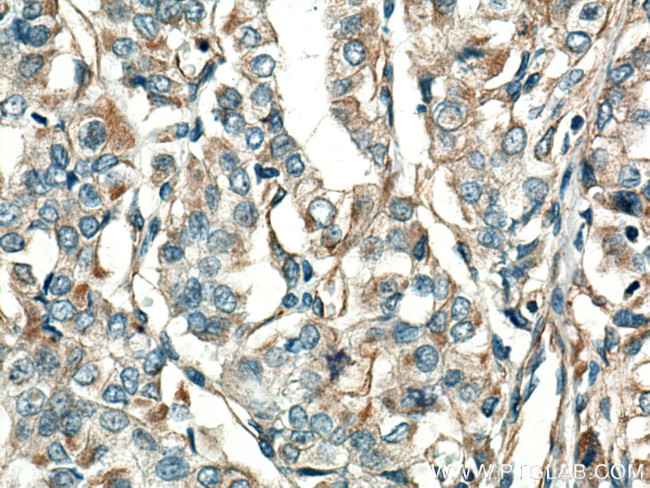
GUK1 Antibody in Immunohistochemistry (Paraffin) (IHC (P))

Search
Proteintech
GUK1 Monoclonal Antibody (2H5E1)
{{$productOrderCtrl.translations['antibody.pdp.commerceCard.promotion.promotions']}}
{{$productOrderCtrl.translations['antibody.pdp.commerceCard.promotion.viewpromo']}}
{{$productOrderCtrl.translations['antibody.pdp.commerceCard.promotion.promocode']}}: {{promo.promoCode}} {{promo.promoTitle}} {{promo.promoDescription}}. {{$productOrderCtrl.translations['antibody.pdp.commerceCard.promotion.learnmore']}}
产品信息
67047-1-IG
种属反应
宿主/亚型
分类
类型
克隆号
抗原
偶联物
形式
浓度
规格
纯化类型
保存液
内含物
保存条件
运输条件
产品详细信息
Aliquoting is unnecessary for -20°C storage.
靶标信息
Guanylate kinase (GK) catalyzes the ATP-dependent phosphorylation of GMP into GDP. It is essential for recycling GMP and indirectly, cGMP. In prokaryotes (such as Escherichia coli), lower eukaryotes (such as yeast) and in vertebrates, GK is a highly conserved monomeric protein of about 200 amino acids. GK has been shown to be structurally similar to protein A57R (or SalG2R) from various strains of Vaccinia virus. Proteins containing one or more copies of the DHR domain, an SH3 domain as well as a C-terminal GK-like domain, are collectively termed MAGUKs (membrane-associated guanylate kinase homologs) and include Drosophila lethal(1)discs large-1 tumor suppressor protein (gene dlg1); mammalian tight junction protein Zo-1; a family of mammalian synaptic proteins that seem to interact with the cytoplasmic tail of NMDA receptor subunits (SAP90/PSD-95, CHAPSYN-110/PSD-93, SAP97/DLG1 and SAP102); vertebrate 55 kD erythrocyte membrane protein (p55); C. elegans protein lin-2; rat protein CASK; and human proteins DLG2 and DLG3. There is an ATP-binding site (P-loop) in the N-terminal section of GK, which is not conserved in the GK-like domain of the above proteins. However these proteins retain the residues known, in GK, to be involved in the binding of MP.
仅用于科研。不用于诊断过程。未经明确授权不得转售。
篇参考文献 (0)
生物信息学
蛋白别名: ATP:GMP phosphotransferase; ATP:GMP-phosphotransferase; GMP kinase; Guanylate kinase; Guanylate kinase 1; GUK1; RP11-520H14.2; unnamed protein product
基因别名: AA409738; AL033299; AL033300; AV026611; GMK; GMPK; Guk-1; GUK1; MTDPS21
UniProt ID: (Human) Q16774, (Mouse) Q64520
Entrez Gene ID: (Human) 2987, (Mouse) 14923, (Rat) 303179